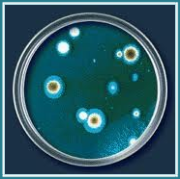

Willkommen
Wir freuen uns, Sie auf unserer Homepage begrüßen zu können. Informieren
Sie sich auf unserer Internetpräsenz über unser Unternehmen und unsere Leistungen. Unser Geschäft stellt Ihnen im Bereich der Gebäudetechnik spezialisiert
auf die Wartung und Instandsetzung von raumlufttechnischen Anlagen eine große
Bandbreite zur Verfügung, aus der Sie ganz nach Ihrem Bedarf wählen können.
Wir betreuen bundesweit Kunden, die unsere Zuverlässigkeit und Fachkompetenz schätzen.Ihr vertrauen und somit die Zufriedenheit ihrer Gäste,Mitarbeiter oder Patienten
haben wir uns zum Ziel gesetzt und arbeiten kontinuierlich zukunftsorientiert an dessen Weiterbestehen.
Auf ihren Wunsch legen wir eine Bestandsliste ihrer raumlufttechnischen Anlagen an.
Daraufhin beraten wir Sie gerne über den zustand ihrer Anlagen und stellen ihnen ein individuelles Wartungskonzept zusammen.
Dabei unterstützen wir Sie mit einer umfassenden und fachlich kompetenten Beratung.
Ihre Raumluft ist zugleich ihre Visitenkarte und mit der erste Eindruck der in ihrem Haus entsteht.
Auch bieten wir die Möglichkeit ihre Haustechniker kompetent und sachlich, spezifisch auf ihre Anlagen zugeschnitten zu
schulen,mit dem Ziel das ihre hauseigenen Techniker die Wartung selbstständig und kostengering durchführen
können.
Gerne stehen wir ihnen für eine persönliche
Beratung zur Verfügung.
Beispiele von Wartungsrückständen
Es geht nicht nur um die Erhaltung der Anlage und deren Funktionssicherheit, sowie eine mögliche Betriebskostenoptimierung, sondern auch vermehrt um das
Verhindern von Krankheiten, die durch eine schlecht gewartete Anlage oder Wartungsrückstände verursacht werden können.
Gerade im klinischen und gastronomischen Bereich ist die Hygiene der lufttechnischen Anlage unerlässlich.Erst durch mehrere Skandale der letzten
Jahre rückt die Raumlufthygiene immer mehr in das bewusstsein der Anlagenbetreiber.
Wartungsrückstände werden auf ihren Wunsch von uns aufgenommen und
dokumentiert,sodas wir diese beseitigen können und wir ihren raumlufttechnischen Anlagen einen störungsfreien
betrieb Gewährleisten.